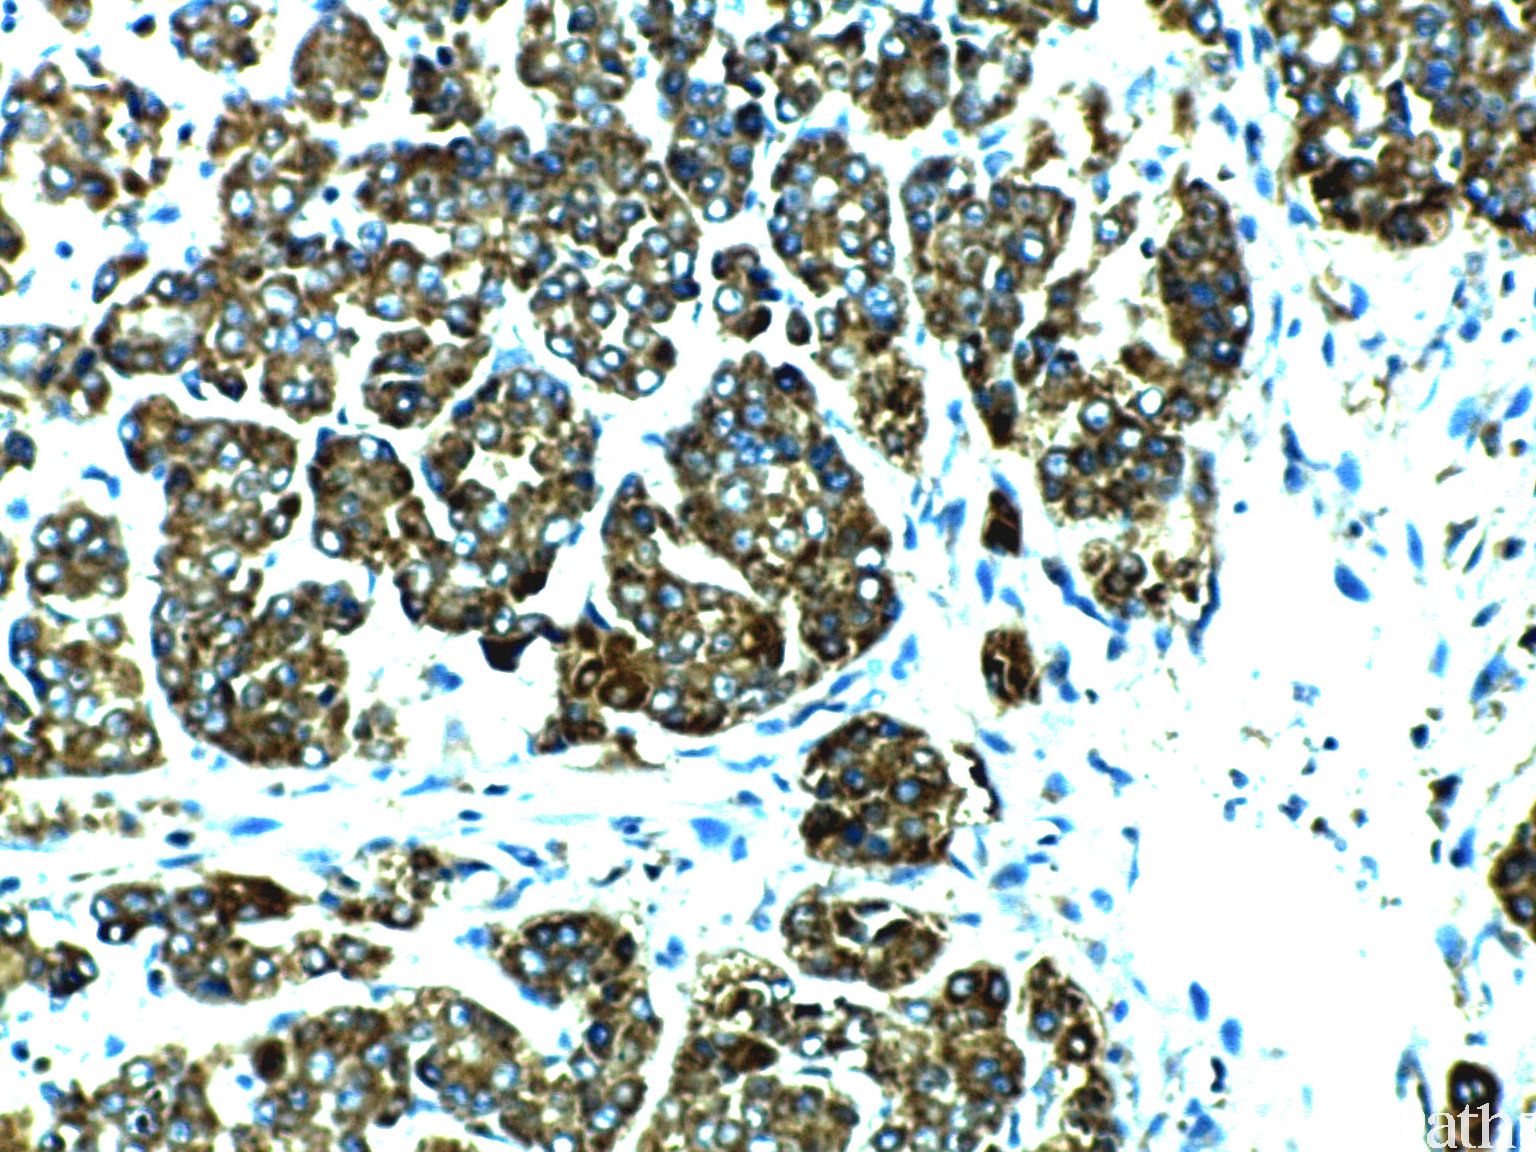

VEGF
别名: Vascular Endothelial Grown Factor
概述:
血管内皮生长因子,广泛分布在各种组织中的血管内皮细胞中。
信号定位: 胞浆
在病理学中的应用:
各种肿瘤中过表达,与肿瘤的生长、浸润及转移相关,与肿瘤的恶性程度呈正相关。
商品化试剂(排名不分先后,本网站对抗体质量不负责!)
公司 | 克隆号 | 即用型(ml) | 原液(ml) | ||||
基因科技 | VG1 | / | 2 | 4 | 7 | / | 0.2 |
中杉金桥 | EP1176Y | 1.5 | 3 | 6 | / | 0.1 | 0.2 |
安必平 | VG1 | 1.5 | 3 | 6 | / | 0.1 | 0.2 |
在肿瘤中的表达情况:
几乎全部阳性(≥95%的病例阳性): 血管内皮细胞瘤,Kaposi 型、前列腺腺泡性癌、乳腺导管原位癌、卵巢卵泡膜细胞瘤、Kaposi 肉瘤、甲状腺间变性癌、鼻血管周细胞瘤、肺鳞状细胞癌、肺淋巴管平滑肌瘤病、视网膜母细胞瘤,NOS、卵巢硬化性间质瘤、甲状腺未分化癌、前列腺高级别上皮内瘤变、乳腺包裹性乳头状癌、淋巴管内乳头状血管内皮瘤、多形性腺瘤、Dabska 肿瘤
通常阳性(<95%,≥75%的病例阳性): 肌上皮瘤、甲状腺髓样癌、腺样囊性癌、胃肠道间质瘤、黏液表皮样癌、淋巴管瘤、皮肤 Merkel 细胞癌、乳腺浸润性癌,非特殊类型、甲状腺腺瘤、肺腺鳞癌、窦岸细胞血管瘤
经常阳性(<75%,≥55%的病例阳性): 结直肠腺癌、甲状腺滤泡性腺瘤、甲状腺滤泡性癌、甲状腺乳头状癌、食管鳞状细胞癌、毛细血管瘤、基底细胞腺瘤、食管腺癌、肺腺癌
有时阳性(<55%,≥35%的病例阳性): 恶性黑色素瘤、膀胱尿路上皮癌、软骨肉瘤、耳鼻喉鳞状细胞癌、血管肉瘤、肝内胆管细胞癌
少数阳性(<35%,≥15%的病例阳性): 血管瘤、胆管癌、胃腺癌
几乎全部阴性(<5%的病例阳性): 上皮样血管内皮瘤、海绵状血管瘤、梭形和上皮样细胞痣、上皮样血管肉瘤、软骨瘤,NOS、细胞性蓝志